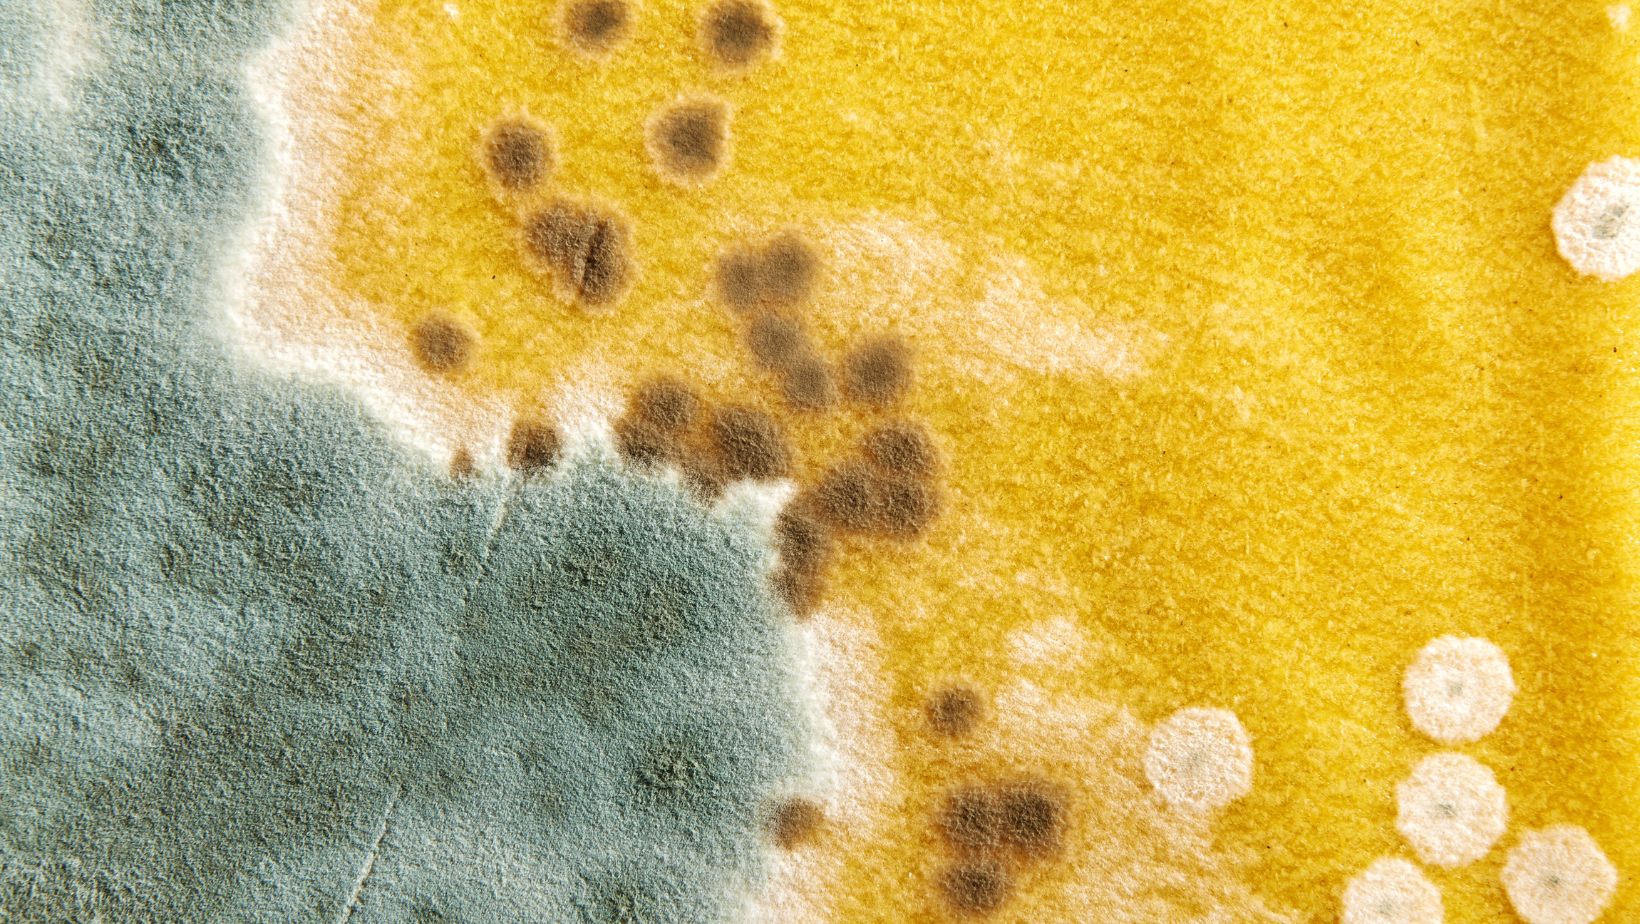

Exploring the Potential Health Effects of Mold in the Environment

Ben Austin is the founder and CEO of multi-award-winning digital…
When people think about mold, their mind will probably go straight to the dangerous fungus that can grow on food left out too long or the game The Last of Us. While mold can be deadly, it also plays an important role in nature and the environment.
In the United States, itโs estimated that at least 7,000 people died from moldย and fungal infections in 2001. According to the Centers for Disease Control and Prevention (CDC), more than 75,000 people in the U.S. are hospitalized every year for fungal infections.
Any healthcare professional, from general practitioners to students of online nursing schoolย programs, can tell you the dangers of mold exposure. This article covers the potential health effects of mold on people and its role in the environment.
What Exactly Is Mold?
Mold is a microorganism and a type of fungus. Although it is a fungus, it is not a mushroom. In nature, it can typically be found growing in wet areas, on damp material, and on decaying organic matter, like dead leaves and animal remains.
Inside, mold grows on damp surfaces and perishables, especially those with high moisture content. There are many factors that contribute to the growth of mold in a building, such as humid conditions, poor ventilation, and leaky pipes.
Despite popular belief, not all types of mold are harmful. Some molds are extremely common in everyday life, like in food or medicine manufacturing. For example, cheese, yogurt, and penicillin (antibiotics) are made with mold.
According to the CDC, the most common indoor molds are:
- Alternaria
- Aspergillus
- Cladosporium
- Penicillium
Potential Health Impact On People
While some molds are harmless, there are a few that can have a dangerous impact on a personโs health, especially if they have allergies or asthma. All types of mold, even if theyโre โharmless,โ can affect an individual with a mold allergy.
When mold is outside, itโs an important part of the ecosystemโbut inside, it can quickly grow to be problematic. In severe cases, it can even lead to infection and death. While having mold in your home wonโt necessarily cause sickness, itโs better to err on the side of caution.

Touching or inhaling mold spores can cause symptomsย such as:
- Runny nose and/or congestion
- Eye irritation
- Sneezing
- Coughing and/or wheezing
- Skin rash
- Lung irritation and a sore throat
- A headache
- Chest tightness
- Shortness of breath
If you ever identify with these common symptoms and thereโs mold in your home, itโs recommended to seek health treatment as soon as possible and deal with the source of the mold. If youโre worried about how to clean it, always seek professional help.
In the United States, it is estimated that as many as 47% of residential buildingsย have mold. It is also estimated that 21% of asthma cases in the U.S. are potentially linked to dampness and mold.
Mold on food is also extremely dangerous. If you ever spot mold on food, immediately discard it and avoid inhaling it. The type of mold that grows on food naturally produces a toxic compound known as mycotoxins.
Mycotoxins are a serious health threat, especially to humans. A small amount of mycotoxins can lead to acute poisoning and even death. Long-term effects of mycotoxin exposure include immune deficiency and cancer.
Diagnosis & Treatment
If you believe youโre experiencing symptoms due to mold exposure, let your doctor know. Removing the mold is also crucial for treatment success and future prevention. Treatment options include:
- Medication, like antihistamine and nasal corticosteroids.
- Allergy shots are recommended if the symptoms are due to a mold allergy.
If you suspect you have a mold allergy, this can be diagnosed by either a general practitioner or a healthcare provider specializing in allergies (like an allergist). They can conduct allergy tests based on your symptoms and the suspected mold allergen.
When it comes to allergy tests, there are typically two options. The first option is a skin prick (scratch) test, which exposes your body to a tiny amount of black mold allergens to see how it reacts.
The second option is for your healthcare provider to request a blood allergy test. A small amount of blood will be withdrawn from your veins, and the sample will be sent to a laboratory to measure the amount of Immunoglobulin E (IGE) that binds to black mold.
When it comes to allergy testing, while blood tests are more convenient, they typically take longer and have a higher rate of false positives.
Mold and the Environment
While mold indoors is less than ideal, it plays a vital role in the Earthโs ecosystem. Mold, the microscopic fungi, exist almost everywhere. They break down and digest organic material like dead leaves. They are essentially natureโs recyclers.
They recycle essential nutrients from decaying organic material and return them to the earth. For example, plants rely on the nutrients that are redistributed by mold in soil, and without them, they wouldnโt be able to grow properly.
Mold is also able to grow and spread rapidly because it essentially multiplies by producing tiny spores. The spores are so small and light that they can float and get carried away by the air. This is also how they get indoors and grow in buildings.
What's Your Reaction?
Ben Austin is the founder and CEO of multi-award-winning digital marketing agency Absolute Digital Media. Ben loves to write and share exclusive insights into the world of digital marketing from his own eyes.